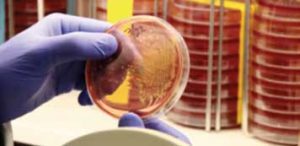
Fall 2015 3

NorTex 2015 Fall Newsletter
September 22, 2015 • NorTex
The North Texas Primary Care Research Network Newsletter
COLLABORATING TO IMPROVE BIRTH OUTCOMES IN TARRANT COUNTY
NorTex is collaborating with Tarrant County Public Health and ForHER to address infant mortality in Tarrant County.
In 2012, Tarrant County led the state in infant deaths among Texas counties with 10,000 or more live births. At 6.87 deaths per 1,000 live births, the Tarrant County infant mortality rate (IMR) was higher than the Texas (5.98 per 1,000) and the United States (5.82 per 1,000) rates. Additionally, there are striking racial and ethnic disparities in infant deaths, with IMRs of 11.7 per 1,000 for African American infants compared to 6.35 for Hispanic, and 5.88 for Non-Hispanic Caucasian infants. There is a substantial and growing body of evidence linking maternal health, across the life course and prior to pregnancy, to future pregnancy outcomes. Because primary care clinicians attend to women across the life course, they are in a unique position to provide preconception health promotion to women and couples of reproductive age during routine encounters.

Reproductive Life Planning is one strategy to address the preconception health of patients. However, training and information on Reproductive Life Planning and how best to deliver this service within the context of primary care is needed. Through our collaboration, we have hosted a continuing education event and will deliver an online survey to clinicians, including primary care providers, pediatricians, OB-GYNs, nurse practitioners, and physician assistants. The goal is to identify educational strategies needed to close the gaps in reproductive life planning. The Preconception Care and Reproductive Life Planning dinner event was hosted at the Fort Worth Club on July 28, 2015. Dr. Janet Shepherd, Clinical Associate Professor in Obstetrics and Gynecology at the University of Colorado School of Medicine, and Dr. Roy Martin, MDiv, DMin, Assistant Professor of Clinical Ethics at Texas College of Osteopathic Medicine, UNT Health Fort Worth, served as the event speakers. The survey will be distributed in September 2015. Improving Birth Outcomes, the Essential Role of Primary Care Providers in Reproductive Life Planning is a collaboration between the Tarrant County Public Health, ForHER, and NorTex at the Science Center. It is part of a grant received from the Texas Department of State Health Services.
NORTEX RESEARCH PROJECTS
FEATURED CURRENT NORTEX PROJECT
Changes in Risk for Type 2 Diabetes Among Mexican American Adolescents
The incidence of Type 2 Diabetes Mellitus has steadily increased over the past decade in American youth, affecting minority populations at a considerably higher rate. In 2013, NorTex collaborated with the Universidad Autónoma del Estado de México (UAEM) to identify if certain psychosocial, family, and environmental factors were associated with the risk of developing Type 2 Diabetes Mellitus in Mexican and Mexican American youth 10 -14 years of age. NorTex is currently conducting a study to assess if these factors are also associated with change in diabetes risk status for Mexican American adolescents. Participants in the original study were identified as high or low risk for developing Type II Diabetes, and parents were provided with results for the child’s cholesterol, blood pressure, glucose, liver enzymes, and depression levels. Providing this information allowed parents to gain insight about their child’s health and open a dialogue about healthy lifestyle changes. Thirty high risk and thirty low risk participants from the first study will be invited to return for a follow-up visit. Identical methods will be utilized for data collection in the current study to assess change in risk status. This study is funded by the Texas Academy of Family Physicians Foundation, and the project will be completed by the end of June 2016. Dr. Kimberly Fulda is the principal investigator.
FEATURED COMPLETED NORTEX PROJECT
In response to the increase of Clostridium Diffcile (C-Diff) cases in the DFW area, NorTex and UNT Health was contracted by the DFW Hospital Council Foundation to conduct environmental sampling of C-Diff in hospitals, outpatient clinics, nursing homes, and long-term care facilities.
A total of 33 facilities (19 hospitals, 11 local and rural primary care clinics, and 3 long-term facilities/nursing homes) participated in the study. The project was completed in December 2014, and a total of 1,386 samples from high touch areas were collected and tested from each facility. High touch areas included computer keyboards, light switches, window blinds/curtains, bed rails, door knobs, restroom sink handles and faucets, and toilet handles. A survey was also conducted to assess the infection control policies and procedures of each facility. Overall C-Diff prevalence was 5.2%, including 6.5% in clinics, 10.3% in long-term care facilities, and 3.8% in hospitals. Prevalence of C-Diff on surfaces varied by healthcare facility. The highest prevalence was found for bed rails (15.2%) and key boards (9.1%) for clinics. Restroom sink handles and faucets as well as bed rails (6.1%) had the highest prevalence for hospitals, and toilet handles (22.22%) had the highest prevalence for long-term care facilities. Survey results indicated that 69.7% of the facilities had specific guidelines for C-Diff infection prevention. The study identified the need for more robust cleaning and infection control measures, with specific attention given to high touch areas. This research will be presented at the annual North American Primary Care Research Group conference in October 2015.
MARK YOUR CALENDARS
September 16th, 2015
Register now for the 14th Annual Infant Health Summit. The Summit, which is organized by the Tarrant County Infant Health Network and the Fatherhood Coalition of Tarrant County, brings together local health care providers, social service providers, public health providers, and community leaders to apply recent scientific advances, policy changes, and public health trends into actions that will improve the health of families and promote responsible fatherhood.

As a continuation of the evening event on July 28th entitled “Improving Birth Outcomes: The Essential Role of Primary Care Providers in Reproductive Life Planning,” the Summit is hosting Dr. Shanna Combs, Assistant Professor in the Department of OB/Gyn at Science Center, to speak on the subject of reproductive life planning in clinical settings. Some of the other presentations include “The Dance of Resilience: Swinging Nature with Nurture over Time” presented by Dr. Richard Adams, Clinical Professor at UT Southwestern Medical Center, and a presentation on the Safe Sleep Initiative led by Cook Children’s Hospital by Dr. Dyann Daley, Board Certified Anesthesiologist and Co-Founder of the Center for the Prevention of Child Maltreatment at Cook Children’s. The Summit is also hosting a mental health panel to discuss steps for providing Psychological First Aid and Compassion Fatigue for when pregnancies and births do not go as planned. The Summit is approved to provide accreditation for Physicians, Continuing Nursing Education, Certified Public Health, and Counselor Texas LPC CEU. Please go to http://ce.unthsc.edu/ to register.
RECENT PUBLICATIONS AND PRESENTATIONS
NorTex research was presented at multiple local, national, and international conferences over the past year! We will also have an oral and poster presentation at the North American Primary Care Research Group annual meeting in October 2015.
PUBLICATIONS
- Cardarelli R, Espinoza A, Fulda KG. (November 2014). “Incidental Computer Tomography Radiologic Findings through Research Participation in the North Texas Healthy Heart Study.” North American Primary Care Research Group Annual Meeting, oral presentation; New York, NY.
- Fulda K, Halliday K, Kasehagen l. (November 2014). “Transition to adult services for youth with special health care needs.” 142nd APHA Annual Meeting and Exposition, poster presentation; New Orleans, LA.
- Fernando S, Fulda K, Franks S, Bowman W, Shah D, Proffit Leyva R, Bawa B, Habiba N. (November 2014). “Comparison of body mass index and percent body fat on risk factors for type 2 diabetes mellitus in children aged 10-14.” 142nd APHA Annual Meeting and Exposition, oral presentation; New Orleans, LA.
- Fulda KG, Lee Joon-hak, Simecka J, Lee M, Pulse M, Espinoza A, Nguyen P, Taylor P, Sharma S. (February 2015). “Clostridium difficile (C-Diff) prevalence in healthcare settings: an environmental screening study in Dallas-Fort Worth region.” 91st TPHA Annual Education Conference, poster presentation; Austin, TX.
- Davis A, Wagner T, Fernando S, Fulda KG, Franks S. (February 2015). “Self-reported diet and risk for Type II Diabetes Mellitus (T2DM) in a low socioeconomic pediatric population.” 91st TPHA Annual Education Conference, poster presentation; Austin, TX.
- Rahman A, Fulda K, Franks S, Lee M, Habiba N.(February 2015). “How often parents make decisions with their children is predictive of adolescent obesity.” 91st TPHA Annual Education Conference, oral presentation; Austin, TX.
- Fernando S, Fulda K, Franks S, Habiba N. (June 2015). “The association between parental perceptions of body norms and child’s risk of T2DM.” Annual Meeting of the Society for Pediatric and Perinatal Epidemiologic Research (SPER), poster presentation; Denver, CO.
- Fernando S, Fulda K, Franks S, Habiba N. (June 2015).“The association between parental belief in self-sufficiency and child’s risk of T2DM.” Annual Meeting of the Society for Pediatric and Perinatal Epidemiologic Research (SPER), poster presentation; Denver, CO.
- Kimberly G. Fulda, DrPH; Randi P. Profftt Leyva, BS; José D. Retana, MPH. (October 2015). “The Association between Acculturation and Risk for Type 2 Diabetes in Mexican-American Children and Adolescents.” North American Primary Care Research Group, poster presentation; Cancun, Mexico.
- Kimberly G. Fulda, Joon-hak lee, Jerry Simecka, Michelle lee, Mark Pulse, Anna Espinoza, Phung Nguyen, Patricia Taylor, Sushma Sharma. (October 2015). “Clostridium difficile (C-Diff) prevalence in healthcare settings: An Environmental Screening Study in Dallas-Fort Worth region”. North American Primary Care Research Group, oral presentation; Cancun, Mexico.
MEMBER HIGHLIGHT:
DR. OLIVAREZ, DO

Dr. Olivarez is a Fort Worth native and private family practice physician. After completing his secondary education in Fort Worth ISD, he attended Baylor University where he majored in Economics. From Waco, he returned to Fort Worth to attend TCOM and finished his residency through the Science Center family practice residency program at the Diamond Hill JPS clinic. He has staffing privileges for hospital work at both Baylor All Saints and Texas Health Resources Southwest. He is currently completing his 13th year of private practice. Dr. Olivarez or Sonny enjoys travel and adventure and Baylor athletics especially football that he shares with his wife, two sons, and mother. He has, through his church, led a medical mission trip to Visakhapatnam, India.

He enjoys medical missions and the travel as well. Dr. Olivarez is highly community minded and spends time at various health fairs in the Fort Worth area and at local school career days. He also enjoys teaching and often has students, including medical students in his office. Dr. Olivarez believes in holistic health for the whole person and the whole family. He values the lives of the families that entrust them with their care. As he would say, “He knows the good and the bad of every family’s lives that affect their personal health.” He is attempting to be one of the few in the DFW area that incorporate complete support for families with all facets of care from physical to mental and spiritual as well. His 4HEALTH concept encourages this idea. His office tag line is “4HEALTH…taking you from health to well-being.

